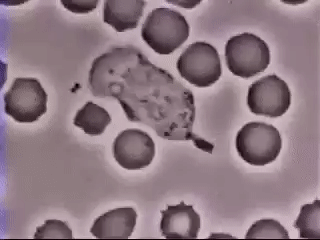

Is web3 a Petri dish?
Arpanet. Internet. The Net. Not such an arrogant label, back when one was all they had. The term cyberspace lasted a bit longer— but space implies great empty vistas, a luminous galaxy of icons and avatars, a hallucinogenic dreamworld in 48-bit color. No sense of the meatgrinder in cyberspace. No hint of pestilence or predation, creatures with split-second lifespans tearing endlessly at each others' throats…
Onion and metabase were more current. New layers were forever being laid atop the old, each free—for a while—from the congestion and static that saturated its predecessors. Orders of magnitude accrued with each generation: more speed, more storage, more power. Information raced down conduits of fiberop, of rotazane, of quantum stuff so sheer its very existence was in doubt. Every decade saw a new backbone grafted onto the beast; then every few years. Every few months. The endless ascent of power and economy proceeded apace, not as steep a climb as during the fabled days of Moore, but steep enough.
And coming up from behind, racing after the expanding frontier, ran the progeny of laws much older than Moore's.
It's the pattern that matters, you see. Not the choice of building materials. Life is information, shaped by natural selection. Carbon's just fashion, nucleic acids mere optional accessories. Electrons can do all that stuff, if they're coded the right way.
It's all just Pattern.
And so viruses begat filters; filters begat polymorphic counteragents; polymorphic counteragents begat an arms race. Not to mention the worms and the 'bots and the single-minded autonomous datahounds—so essential for legitimate commerce, so vital to the well-being of every institution, but so needy, so demanding of access to protected memory. And way over there in left field, the Artificial Life geeks were busy with their Core Wars and their Tierra models and their genetic algorithms. It was only a matter of time before everyone got tired of endlessly reprogramming their minions against each other. Why not just build in some genes, a random number generator or two for variation, and let natural selection do the work?
The problem with natural selection, of course, is that it changes things.
The problem with natural selection in networks is that things change fast.
…If you could watch the fornication and predation and speciation without going grand mal from the rate-of-change, you knew there was only one word that really fit: Maelstrom.
Of course, people still went there all the time. What else could they do? Civilization's central nervous system had been living inside a Gordian knot for over a century. No one was going to pull the plug over a case of pinworms.
Peter Watts, 2001, “Maelstrom”

Evolution is a behavior that emerges in any system with:
Mutation
Heredity
Selection
How far are we from Maelstrom today?
It’s no secret that the Ethereum blockchain is a highly adversarial environment. If a smart contract can be exploited for profit, it eventually will be. The frequency of new hacks indicates that some very smart people spend a lot of time examining contracts for vulnerabilities.
But this unforgiving environment pales in comparison to the mempool (the set of pending, unconfirmed transactions). If the chain itself is a battleground, the mempool is something worse: a dark forest.
In the Ethereum mempool, these apex predators take the form of “arbitrage bots.” Arbitrage bots monitor pending transactions and attempt to exploit profitable opportunities created by them.
Arbitrage bots typically look for specific types of transactions in the mempool (such a DEX trade or an oracle update) and try to frontrun them according to a predetermined algorithm. Generalized frontrunners look for any transaction that they could profitably frontrun by copying it and replacing addresses with their own. They can even execute the transaction and copy profitable internal transactions generated by its execution trace.
Robinson, Konstantopoulos, 2020, “Ethereum is a Dark Forest”
I have a disturbing sense that this question is the wrong way around. What problem does a case of pinworms solve? Or a rainforest? What problem do I solve?
The species is fundamentally Aim-Less (it finds its goals as it goes along).
W. Ross-Ashby
Ecosystems can't possibly exist for a particular purpose.
Hayao Miyazaki
Evolving systems don’t serve any purpose. They propagate. Maybe cryptocurrency is like this? Maybe markets are like this. Maybe rainforests are like this. Maybe more systems are like this than we care to recognize.
A virus may spread, or may die out. Web3 may spread, or may die out. But asking an evolving system what problem it solves will not reveal much about its viability.
An evolutionary system doesn’t need teleology to be viable. It propagates. Other outcomes, beneficial, harmful, are byproducts. Like fruit growing on a tree, or a virus giving you a cough. We may project purposes onto these byproducts, but those purposes aren’t what drive the system.
Are blockchains a petri dish for something else?
Yikes. Eldritch energy.